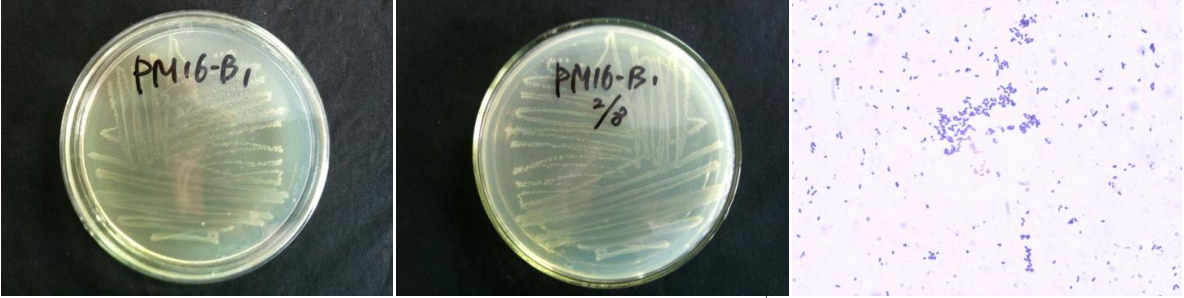

Loading...
| StrainNO | B362 |
| Classification | Acinetobacter |
| 16s rDNA sequence | CCCCTCGGGCCCCCCGGTGGTAAGCGTCCTCCTTGCGGTTAGACTACCTACTTCTGGTGCACAAACTCCCATGGTGTGACGGGCG GTGTGTACAAGGCCCGGGAACGTATTCACCGCGGCATTCTGATCCGCGATTACTAGCGATTCCGACTTCACGCAGTCGAGTTGCA GACTGCGATCCGGACTACGATCGGCTTTTTGAGATTAGCATCCTCTCGCGAGGTAGCAACCCTTTGTACCGACCATTGTAGCACG TGTGTAGCCCTGGCCGTAAGGGCCATGATGACTTGACGTCGTCCCCGCCTTCCTCCAGTTTGTCACTGGCAGTATCCTTAAAGTT CCCGGCATTACCCGATGGCAAATAAGGAAAAGGGTTGCGCTCGTTGCGGGACTTAACCCAACATCTCACGACACGAGCTGACGAC AGCCATGCAGCACCTGTATCTAAGTTCCCGAAGGCACCAATCCATCTCTGGAAAGTTCTTAGTATGTCAAGGCCAGGTAAGGTTC TTCGCGTTGCATCGAATTAAACCACATGCTCCACCGCTTGTGCGGGCCCCCGTCAATTCATTTGAGTTTTAGTCTTGCGACCGTA CTCCCCAGGCGGTCTACTTATCGCGTTAGCTGCGCCACTAAAGCCTCAAAGGCCCCAACGGCTAGTAGACATCGTTTACGGCATG GACTACCAGGGTATCTAATCCTGTTTGCTCCCCATGCTTTCGTACCTCAGCGTCAGTATTAGGCCAGATGGCTGCCTTCGCCATC GGTATTCCTCCAGATCTCTACGCATTTCACCGCTACACCTGGAATTCTACCATCCTCTCCCATACTCTAGCTTTCCAGTATCGAA TGCAATTCCTAAGTTAAGCTCAGGGATTTCACATCCGACTTAAAAAGCCGCCTACGCACGCTTTACGCCCAGTAAATCCGATTAA CGCTCGCACCCTCTGTATTACCGCGGCTGCTGGCACAGAGTTAGCCGGTGCTTATTCTGCGAGTAACGTCCACTCTCTTTAGGTA TTAACTAAAGGAGCCTCCTCCTCGCTTAAAGTGCTTTACAACCAAAAGGCCTTCTTCACACACGCGGCATGGCTGGATCAGGCTT CCGCCCATTGTCCAATATTCCCCACTGCTGCCTCCCGTAGGAGTCTGGGCCGTGTCTCAGTCCCAGTGTGGCGGATCATCCTCTC AGACCCGCTACAGATCGTCGCCTTGGTAGGCCTTTACCCCACCAACTAGCTAATCCGACTTAGGCTCATCTATTAGCGCAAGGTC CGAAGATCCCCTGCTTTCCCCCGTAGGGCGTATGCGGTATTAGCGTTCCTTTCGGAACGTTGTCCCCCACTAATAGGCAGATTCC TAAGCATTACTCACCCGTCCGCCGCTAGGTCAGTTACCGAAGCAACCTTCCCCGCTCGACTTGCATGGTAAGCCGCCCCCCCCTC GCC |
| Strain Morphology Photos | |
| Morphological Description | Colony round;clam white;edge neatly;steamed bun shaped;slippy;sticky;translucent;Bacteriophage Rod-shaped;Coccidioides paired;no spore |